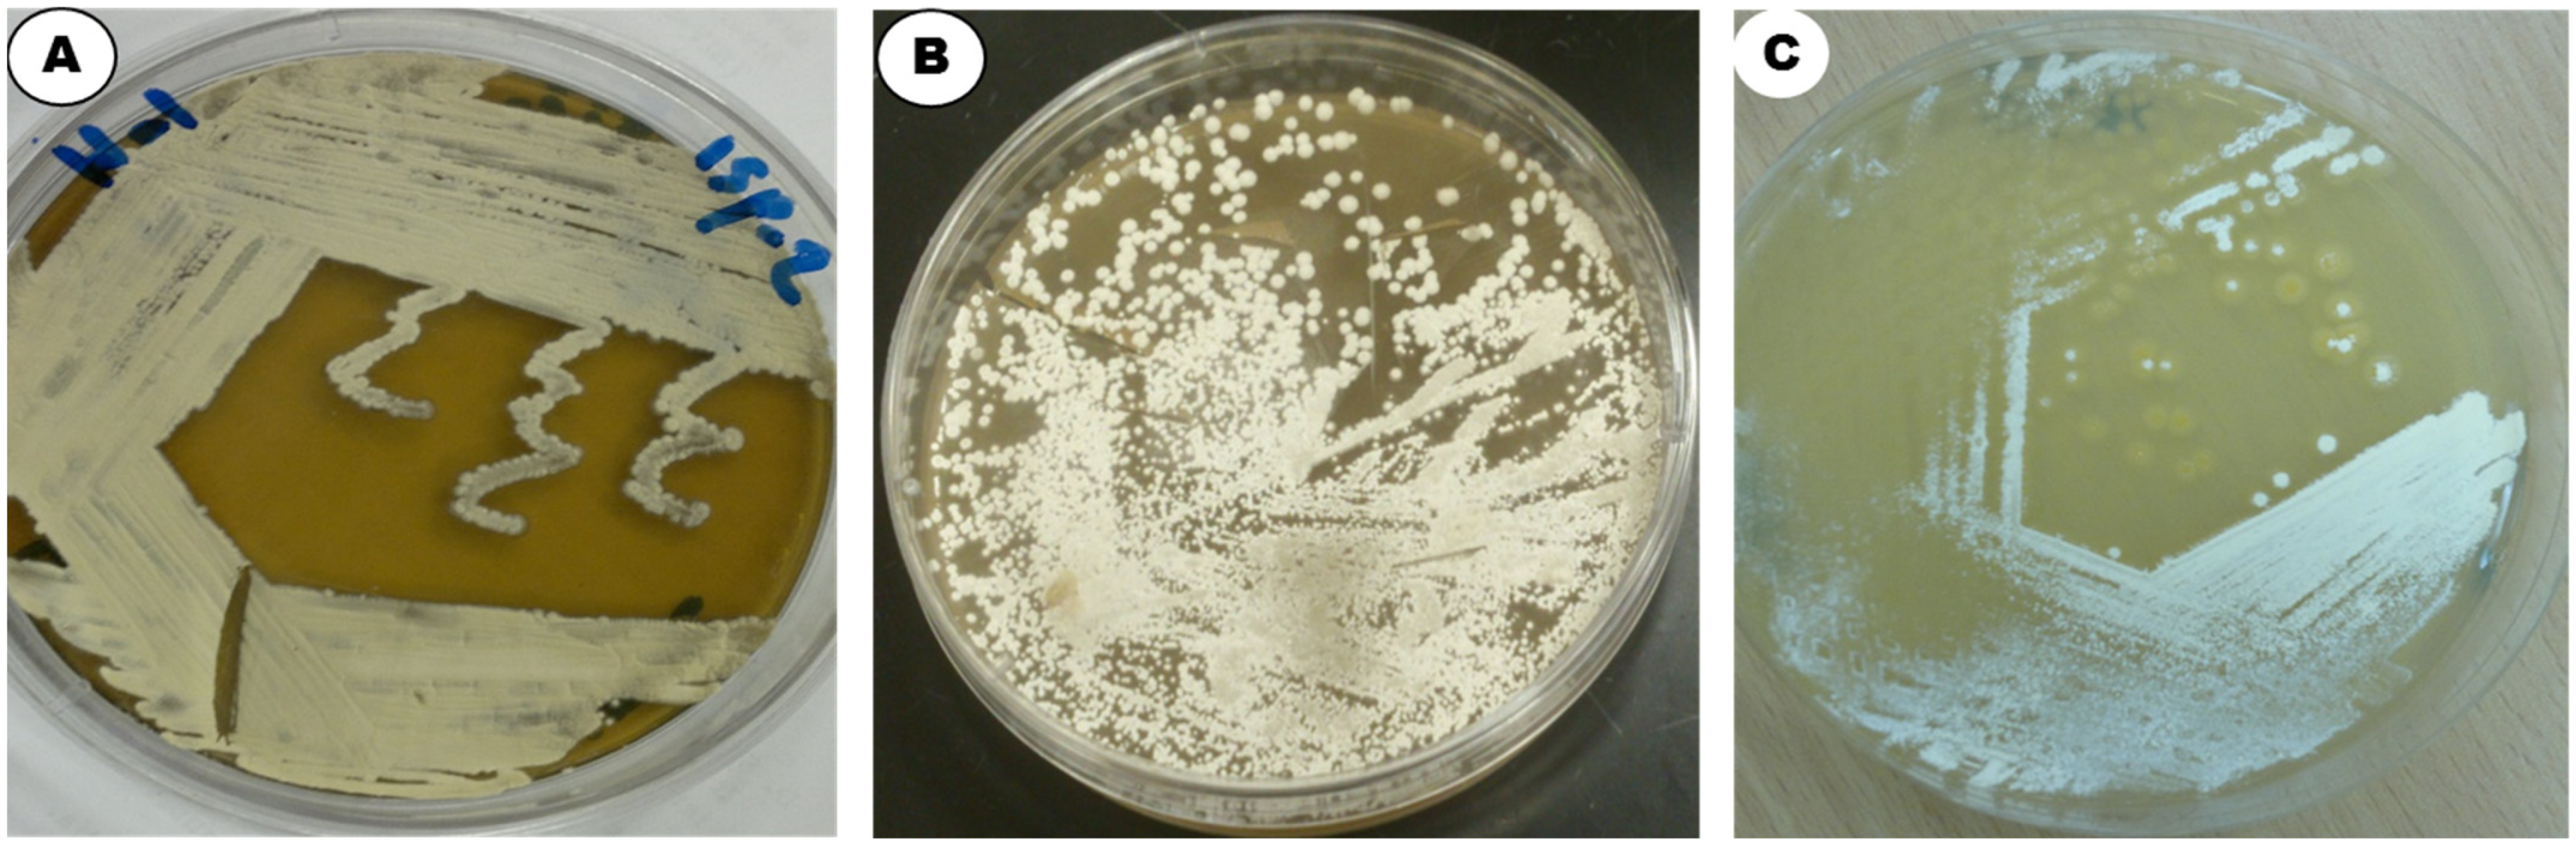
Applsci 12 12257 g002
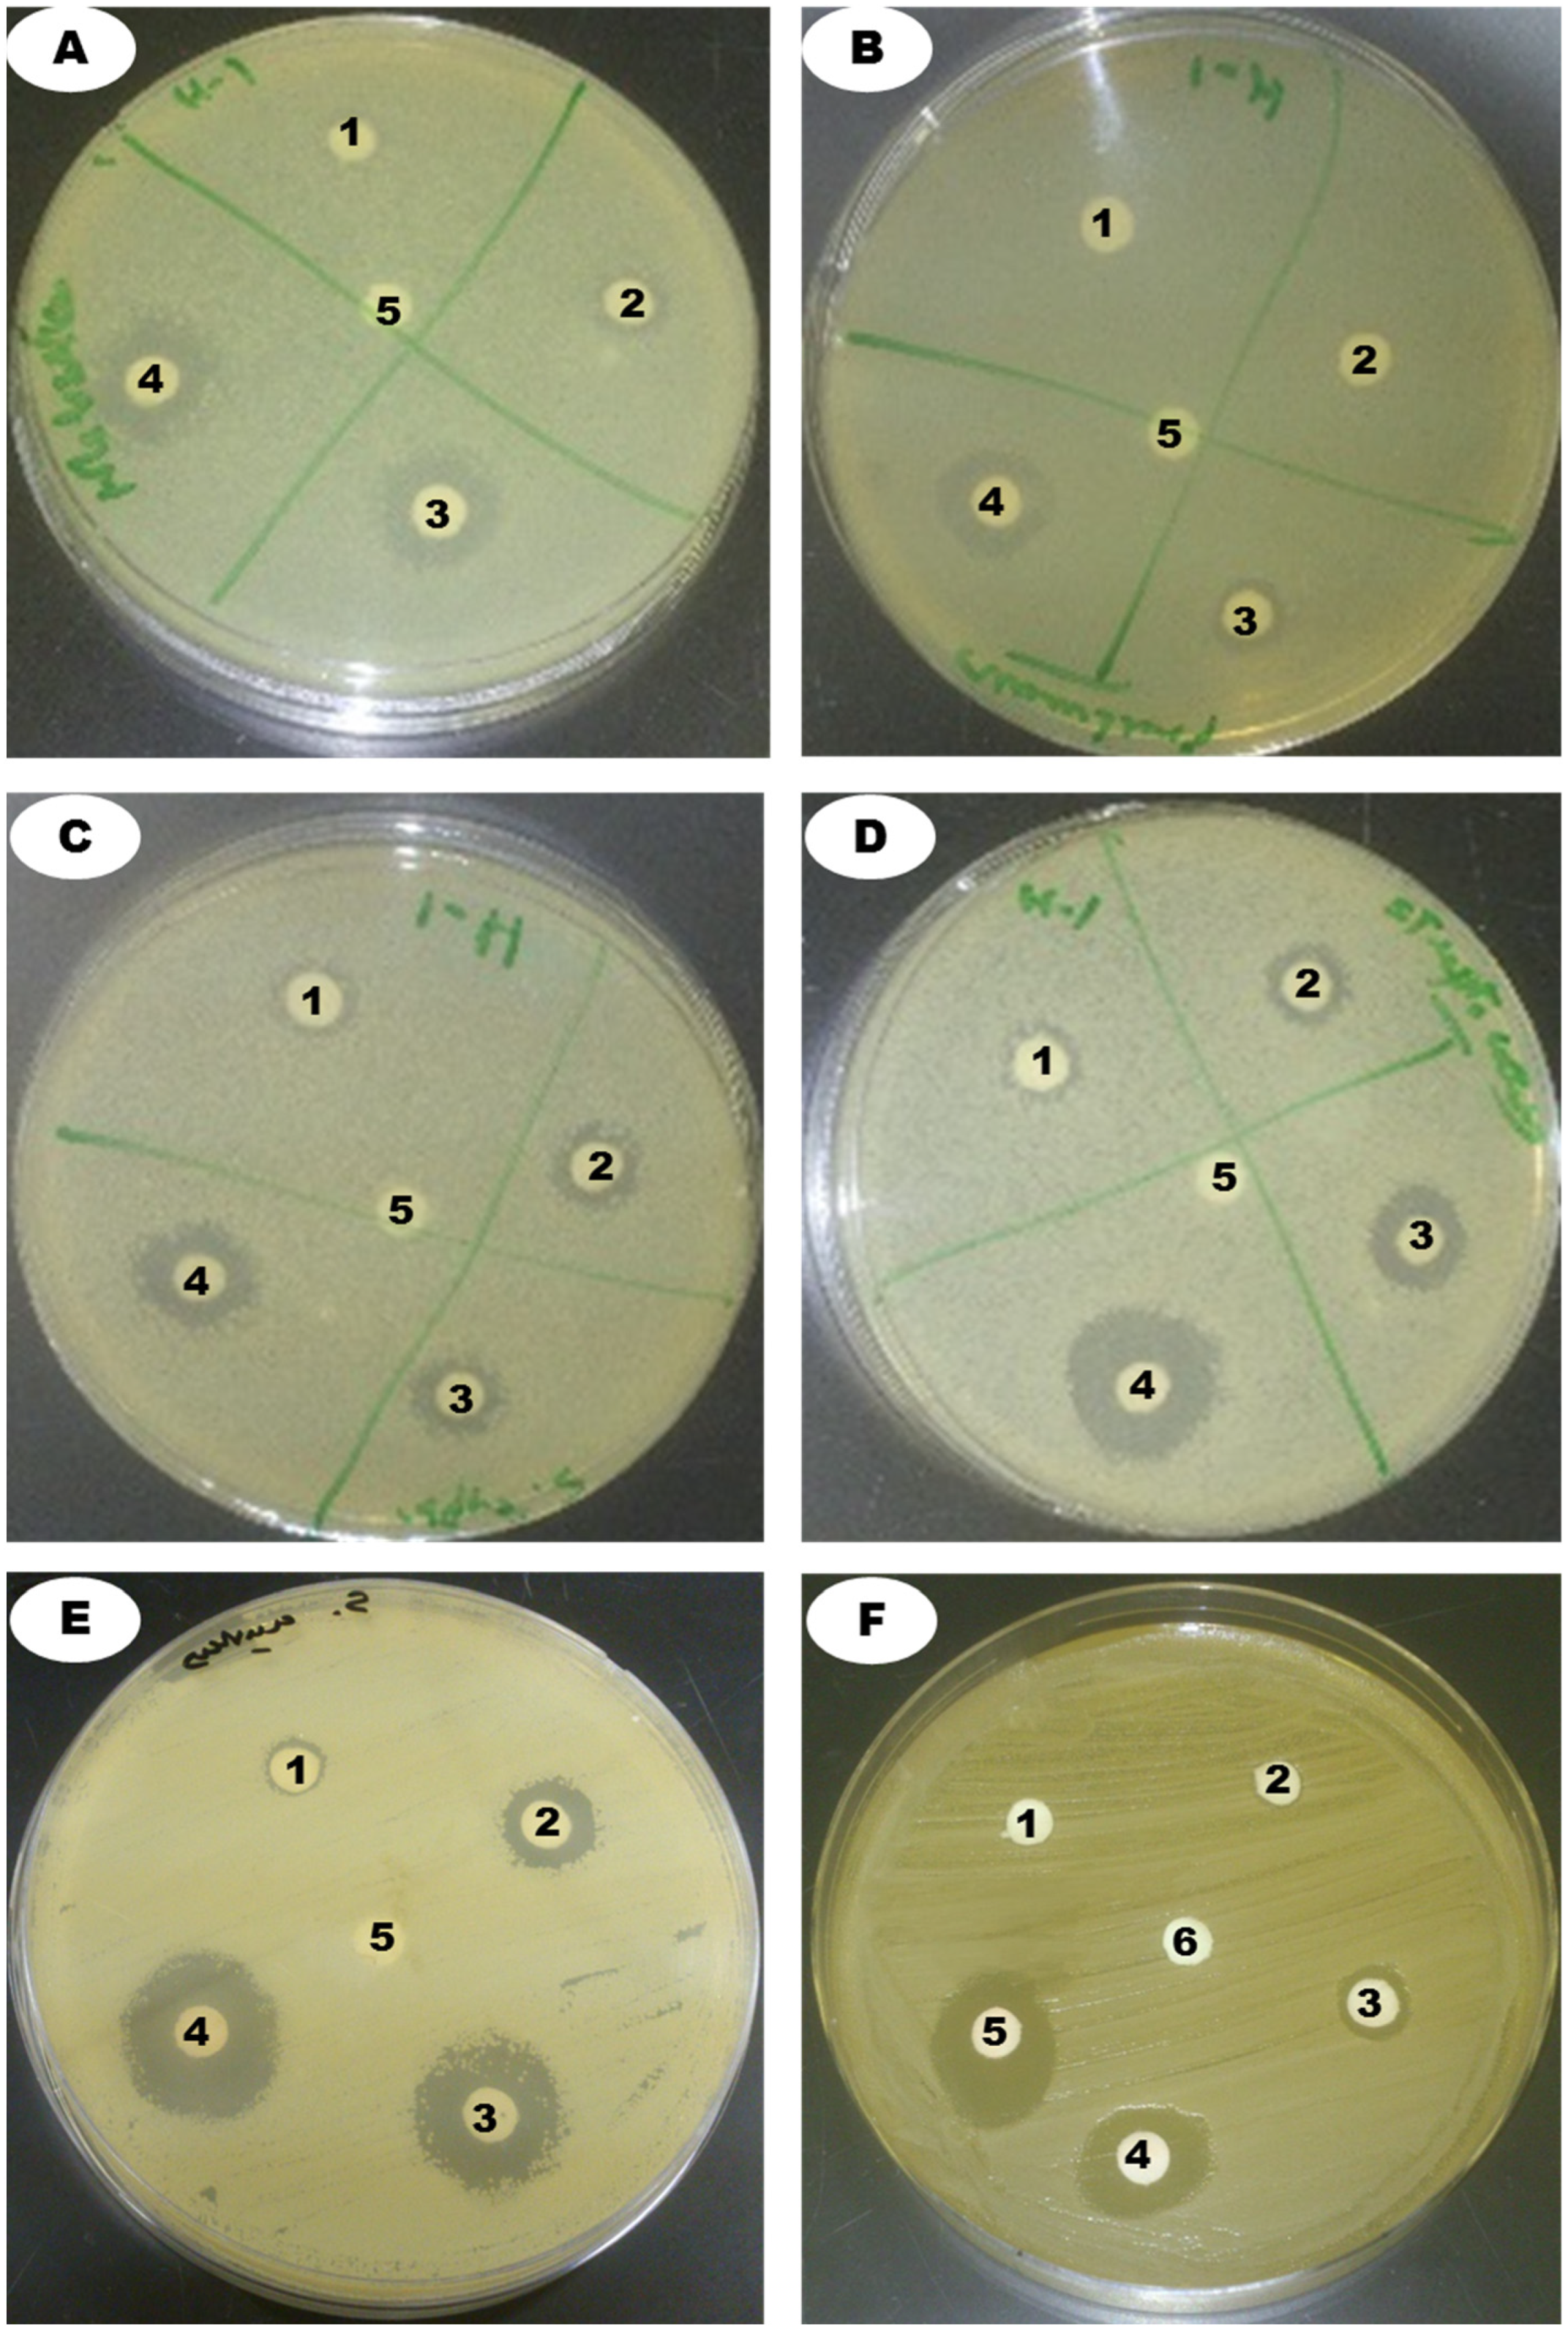
Applsci 12 12257 g006

Metabolic Profiling of Streptomyces sp. Strain ess_amH1 Isolated from Apis mellifera yemintica’s Gut Microbiome, and Its Anticancer Activity against Breast Cancer (MCF7) and Hepatocarcinoma (HepG2) Cell Lines, as Well as Antimicrobial Activity
Abstract
1. Introduction
2. Materials and Methods
2.1. Sample Collection
2.2. Isolation of Actinomycetes from A. mellifera Yemintica
2.3. Morphological Characteristics of Streptomyces sp. Strain ess_amH1
2.4. Biochemical Characteristics of Streptomyces sp. Strain ess_amH1
2.5. Molecular Characterization of Strain
2.6. Extraction of Secondary Metabolites from Streptomyces sp. Strain ess_amH1
2.7. GC–MS Analysis
2.8. Antimicrobial Activity of the Extract of Streptomyces sp. Strain ess_amH1 against Bacterial and Fungal Pathogens (Disc Diffusion Assay)
2.9. SEM Examination
2.10. Antiproliferative Activity of the Crude Extract
2.11. Statistical Analysis
3. Results
3.1. Isolation and Identification of the Strain ess_amH1
3.2. Molecular Identification of the Strain ess_amH1
3.3. GC–MS Analysis of Strain ess_amH1
3.4. Antimicrobial Activity of the Strain ess_amH1
Cell Morphology by SEM Examination
3.5. Antiproliferative Activity of the EtoAc Extract of ess_amH1
4. Discussion
5. Conclusions
Author Contributions
Funding
Institutional Review Board Statement
Informed Consent Statement
Data Availability Statement
Conflicts of Interest
References
- Emerson, R.; Procópio, D.L.; Reis, I.; Kassawara, M.; Lúcio, J.; Azevedo, D.; Magali, J.; Araújo, D. Review article Antibiotics produced by Streptomyces. Braz. J. Infect. Dis. 2012, 16, 466–471. [Google Scholar]
- Kafilzadeh, F.; Dehdari, F. Amylase activity of aquatic actinomycetes isolated from the sediments of mangrove forests in south of Iran. Egypt J. Aquat. Res. 2015, 41, 197–201. [Google Scholar] [CrossRef]
- Kumari, N.; Menghani, E.; Mithal, R. GCMS analysis of compounds extracted from actinomycetes AIA6 isolates and study of its antimicrobial efficacy. Ind. J. Chem. Tech. 2019, 26, 4. [Google Scholar]
- Higginbotham, S.J.; Murphy, C.D. Identification and characterisation of a Streptomyces sp. isolate exhibiting activity against methicillin-resistant Staphylococcus aureus. Microbiol. Res. 2010, 165, 82–86. [Google Scholar] [CrossRef]
- Wiese, J.; Imhoff, J.F. Marine bacteria and fungi as promising source for new antibiotics. Drug Dev. Res. 2019, 80, 24–27. [Google Scholar] [CrossRef]
- Abdelmohsen, U.R.; Balasubramanian, S.; Oelschlaeger, T.A.; Grkovic, T.; Pham, N.B.; Quinn, R.J.; Hentschel, U. Potential of marine natural products against drug-resistant fungal, viral, and parasitic infections. Lancet Infect. Dis. 2017, 17, e30–e41. [Google Scholar] [CrossRef]
- Clardy, J.; Fischbach, M.A.; Currie, C.R. The natural history of antibiotics. Curr. Biol. 2009, 19, R437–R441. [Google Scholar] [CrossRef]
- Zhalnina, K.; Zengler, K.; Newman, D.; Northen, T.R. Need for laboratory ecosystems to unravel the structures and functions of soil microbial communities mediated by chemistry. MBio 2018, 9, e01175-18. [Google Scholar] [CrossRef]
- Zipperer, A.; Konnerth, M.C.; Laux, C.; Berscheid, A.; Janek, D.; Weidenmaier, C.; Burian, M.; Schilling, N.A.; Slavetinsky, C.; Marschal, M.; et al. Human commensals producing a novel antibiotic impair pathogen colonization. Nature 2016, 535, 511–516. [Google Scholar] [CrossRef]
- Currie, C.R.; Wong, B.; Stuart, A.E.; Schultz, T.R.; Rehner, S.A.; Mueller, U.G.; Sung, G.-H.; Spatafora, J.W.; Straus, N.A. Ancient tripartite coevolution in the attine ant-microbe symbiosis. Science 2003, 299, 386–388. [Google Scholar] [CrossRef]
- Kroiss, J.; Kaltenpoth, M.; Schneider, B.; Schwinger, M.G.; Hertweck, C.; Maddula, R.K.; Strohm, E.; Svatos, A. Symbiotic streptomycetes provide antibiotic combination prophylaxis for wasp offspring. Nat. Chem. Biol. 2010, 6, 261–263. [Google Scholar] [CrossRef]
- Oh, D.C.; Poulsen, M.; Currie, C.R.; Clardy, J. Dentigerumycin: A bacterial mediator of an ant-fungus symbiosis. Nat. Chem. Biol. 2009, 5, 391–393. [Google Scholar] [CrossRef]
- Scott, J.J.; Oh, D.C.; Yuceer, M.C.; Klepzig, K.D.; Clardy, J.; Currie, C.R. Bacterial protection of beetle-fungus mutualism. Science 2008, 322, 63. [Google Scholar] [CrossRef]
- Chevrette, M.G.; Carlson, C.M.; Ortega, H.E.; Thomas, C.; Ananiev, G.E.; Barns, K.J.; Book, A.J.; Cagnazzo, J.; Carlos, C.; Flanigan, W.; et al. The antimicrobial potential of Streptomyces from insect microbiomes. Nat. Commun. 2019, 10, 516. [Google Scholar] [CrossRef]
- Shirling, E.B.; Gottlieb, D. Methods for characterization of Streptomyces species. Int. J. Syst. Bact. 1966, 16, 313–340. [Google Scholar] [CrossRef]
- Mohanasrinivasan, V.; SriramKalyan, P.; Ipsita, N.; Subathradevi, C.; Selvarajan, E.; Suganthi, V.; Jemimah, N.S. Fermentative production of extracellular pigment from Streptomyces coelicolor MSIS1. Res. J. Biotech. 2013, 8, 31–41. [Google Scholar]
- Holding, A.J.; Collee, J.G. Routine Biochemical Tests. Methods Microbiol. 1971, 6, 1–32. [Google Scholar]
- Sambrook, J.; Fritsch, E.F.; Maniatis, T. Molecular Cloning: A Laboratory Manual, 2nd ed.; Cold Spring Harbor Laboratory Press: Cold Spring Harbor, NY, USA, 1989. [Google Scholar]
- Sasikala, K.; Chandra Mohan, S. Total phenolic, Flavanoid contents and GC-MS analysis of canthium coromandelicum leaves extract. Int. J. Pharm. Pharmaceut. Sci. 2014, 6, 379–381. [Google Scholar]
- de Souza Constantino, L.; da Rosa Guimarães, T.; de Oliveira, S.Q.; Bianco, É.M.; de Souza Pessoa, L.G.; Michels, M.; Schenkel, E.P.; Pizzol, F.D.; Reginatto, F.H. TSH fraction from Petromica citrina: A potential marine natural product for the treatment of sepsis by Methicillin-resistant Staphylococcus aureus (MRSA). Biomed. Pharmacother. 2018, 108, 1759–1766. [Google Scholar] [CrossRef]
- Shukla, S. Studying antimicrobial-induced morphostructural damage of bacteria by scanning electron microscope. Bangladesh J. Pharmacol. 2015, 10, 870–874. [Google Scholar] [CrossRef]
- Elmaidomy, A.H.; Mohyeldin, M.M.; Ibrahim, M.M.; Hassan, H.M.; Amin, E.; Rateb, M.E.; Hetta, M.H.; El Sayed, K.A. Acylated Iridoids and Rhamnopyranoses from Premna odorata (Lamiaceae) as Novel Mesenchymal–Epithelial Transition Factor Receptor Inhibitors for the Control of Breast Cancer. Phytother. Res. 2017, 31, 1546–1556. [Google Scholar] [CrossRef]
- Dembitsky, V.M. Bioactive cyclobutane-containing alkaloids. J. Nat. Med. 2008, 62, 1–33. [Google Scholar] [CrossRef]
- Shoaib, M. Synthesis, Antibacterial and Antifungal Properties of Cyclohexane Tosyloxyimine Derivative. J. Microbiol. Biotechnol. 2019, 4, 000150. [Google Scholar]
- Reddy, D.N.; Al-Rajab, A.J. Chemical composition, antibacterial and antifungal activities of Ruta graveolens L. volatile oils. Cogent Chem. 2016, 2, 1220055. [Google Scholar] [CrossRef]
- Bisignano, G.; Laganà, M.G.; Trombetta, D.; Arena, S.; Nostro, A.; Uccella, N.; Mazzanti, G.; Saija, A. In vitro antibacterial activity of some aliphatic aldehydes from Olea europaea L. FEMS Microbiol. Lett. 2001, 198, 9–13. [Google Scholar] [CrossRef]
- Caboni, P.; Ntalli, N.G.; Aissani, N.; Cavoski, I.; Angioni, A. Nematicidal activity of (E, E)-2,4-decadienal and (E)-2-decenal from Ailanthus altissima against Meloidogyne javanica. J. Agric. Food Chem. 2012, 60, 1146–1151. [Google Scholar] [CrossRef]
- Trombetta, D.; Saija, A.; Bisignano, G.; Arena, S.; Caruso, S.; Mazzanti, G.; Castelli, F. Study on the mechanisms of the antibacterial action of some plant α,β-unsaturated aldehydes. Lett. Appl. Microbiol. 2002, 35, 285–290. [Google Scholar] [CrossRef]
- Guo, L.; Wu, J.Z.; Han, T.; Cao, T.; Rahman, K.; Qin, L.P. Chemical composition, antifungal and antitumor properties of ether extracts of Scapania verrucosa Heeg. and its endophytic fungus Chaetomium fusiforme. Molecules 2008, 13, 2114–2125. [Google Scholar] [CrossRef]
- Negi, K.; Tewari, S.D.; Chaturvedi, P. Antibacterial activity of marchantia papillata raddi subsp. Grossibarba (Steph.) Bischl. Against staphylococcus aureus. Indian J. Tradit. Knowl. 2018, 17, 763–769. [Google Scholar]
- Khaled, J.M.; Alharbi, N.S.; Mothana, R.A.; Kadaikunnan, S.; Alobaidi, A.S. Biochemical Profile by GC–MS of Fungal Biomass Produced from the Ascospores of Tirmania nivea as a Natural Renewable Resource. J. Fungi 2021, 7, 1083. [Google Scholar] [CrossRef]
- Tsukuda, Y.; Mizuhara, N.; Usuki, Y.; Yamaguchi, Y.; Ogita, A.; Tanaka, T.; Fujita, K. Structure–activity relationships of antifungal phenylpropanoid derivatives and their synergy with n-dodecanol and fluconazole. Lett. Appl. Microbiol. 2022, 74, 377–384. [Google Scholar] [CrossRef] [PubMed]
- Babar, A.G. Antifungal activity and investigation of bioactive compounds of marine intertidal bivalve Gafrarium divaricatum from West coast of India. Int. J. Pure Appl. Biosci. 2016, 4, 211–217. [Google Scholar] [CrossRef]
- Arora, S.; Kumar, G.; Meena, S. Screening and evaluation of bioactive components of cenchrus ciliaris l. by GC-MS ANALYSIS. Int. Res. J. Pharm. 2017, 8, 69–76. [Google Scholar] [CrossRef]
- Chien, C.C.; Chou, M.Y.; Chen, C.Y.; Shih, M.C. Analysis of genetic diversity of Xanthomonas oryzae pv. oryzae populations in Taiwan. Sci. Rep. 2019, 9, 316. [Google Scholar] [CrossRef] [PubMed]
- Figueiredo, C.; Matsuo, A.; Pereira, F.; Rabaca, A.; Farias, C.; Girola, N.; Massaoka, M.H.; A Azevedo, R.; Scutti, J.A.; Arruda, D.C.; et al. Pyrostegia venusta heptane extract containing saturated aliphatic hydrocarbons induces apoptosis on B16F10-Nex2 melanoma cells and displays antitumor activity in vivo. Pharmacogn. Mag. 2014, 10, S363. [Google Scholar] [CrossRef]
- Nithya, T.G.; Jayanthi, J.; Raghunathan, M.G. Phytochemical, antibacterial and GC MS analysis of a floating fern salvinia molesta D.S. Mitchell (1972). Int. J. PharmTech Res. 2015, 8, 85–90. [Google Scholar]
- Duart, M.J.; García-Domenech, R.; Gálvez, J.; Alemán, P.A.; Martín-Algarra, R.V.; Antón-Fos, G.M. Application of a mathematical topological pattern of antihistaminic activity for the selection of new drug candidates and pharmacology assays. J. Med. Chem. 2006, 49, 3667–3673. [Google Scholar] [CrossRef]
- Ganesh, M.; Mohankumar, M. Extraction and identification of bioactive components in Sida cordata (Burm.f.) using gas chromatography–mass spectrometry. J. Food Sci. Technol. 2017, 54, 3082–3091. [Google Scholar] [CrossRef]
- Trust, T.J.; Bartlett, K.H. Antibacterial activity of tropilidine and tropone. Antimicrob. Agents Chemother. 1975, 8, 381–383. [Google Scholar] [CrossRef]
- Van Arnam, E.B.; Ruzzini, A.C.; Sit, C.S.; Horn, H.; Pinto-Tomás, A.A.; Currie, C.R.; Clardy, J. Selvamicin, an atypical antifungal polyene from two alternative genomic contexts. Proc. Natl. Acad. Sci. USA 2016, 113, 12940–12945. [Google Scholar] [CrossRef]
- Evangelista-Martínez, Z. Preliminary Study on Some Actinomycetes and Evaluation of Their Potential Antagonism against Fungal Pathogens. Br. Microbiol. Res. J. 2014, 4, 272. [Google Scholar] [CrossRef]
- Voirol, L.R.P.; Frago, E.; Kaltenpoth, M.; Hilker, M.; Fatouros, N.E. Bacterial symbionts in lepidoptera: Their diversity, transmission, and impact on the host. Front. Microbiol. 2018, 9, 556. [Google Scholar] [CrossRef]
- Malviya, M.K.; Pandey, A.; Sharma, A.; Tiwari, S.C. Characterization and identification of actinomycetes isolated from “fired plots” under shifting cultivation in northeast Himalaya, India. Ann. Microbiol. 2013, 63, 561–569. [Google Scholar] [CrossRef]
- Ndonde, M.J.M.; Semu, E. Preliminary characterization of some Streptomyces species from four Tanzanian soils and their antimicrobial potential against selected plant and animal pathogenic bacteria. World J. Microbiol. Biotechnol. 2000, 16, 595–599. [Google Scholar] [CrossRef]
- Zhao, J.; Han, L.; Yu, M.; Cao, P.; Li, D.; Guo, X.; Liu, Y.; Wang, X.; Xiang, W. Characterization of Streptomyces sporangiiformans sp. Nov., a novel soil actinomycete with antibacterial activity against Ralstonia solanacearum. Microorganisms 2019, 7, 360. [Google Scholar] [CrossRef]
- Kurnianto, M.A.; Kusumaningrum, H.D.; Lioe, H.N. Characterization of Streptomyces Isolates Associated with Estuarine Fish Chanos chanos and Profiling of Their Antibacterial Metabolites-Crude-Extract. Int. J. Microbiol. 2020, 2020, 8851947. [Google Scholar] [CrossRef]
- Siddique, S.; Syed, Q.; Adnan, A.; Ashraf Qureshi, F. Isolation, characterization and selection of avermectin-producing Streptomyces avermitilis strains from soil samples. Jundishapur J. Microbiol. 2014, 7, e10366. [Google Scholar] [CrossRef]

| Parameter/ Medium | Color of AM | Color of SM | AM/SM | Growth | Form of Spore Chain | Pigmentation |
|---|---|---|---|---|---|---|
| ISP-2 | White | Yellow | AM | Good | Flexibilis | Oil yellow |
| ISP-4 | White | Light white | AM | Good | Flexibilis | - |
| ISP-5 | Creamy white | Light white | AM | Moderate | Flexibilis | - |
| ISP-6 | Yellowish white | Light white | AM | Good | Flexibilis | - |
| ISP-7 | White | Light white | AM | Good | Flexibilis | |
| Czapex Dox | White | Light white | AM | Poor | Flexibilis | - |
| Starch casein agar | White | Light yellow | AM | Good | Flexibilis |
| Growth at Different Conc. NaCl | |
|---|---|
| 1% | +++ |
| 4% | + |
| 7% | − |
| 10% | − |
| 14% | − |
| Growth at Different pH | |
| 5 | − |
| 7 | + |
| 10 | − |
| Growth at Different Temperatures (°C) | |
| 4 | − |
| 26 | ++ |
| 30 | +++ |
| 37 | + |
| 45 | − |
| Enzyme Activity | |
|---|---|
| Amylase | + |
| DNase | − |
| Catalase | + |
| Hydrolysis of esculin | + |
| H2S production | − |
| Protease | + |
| Lecithin hydrolysis | − |
| Lipid hydrolysis | + |
| Urea hydrolysis | + |
| Nitrate reduction | + |
| Chitinase | + |
| Carbon Sources | |
|---|---|
| Arabinose | − |
| Fructose | + |
| D-xylose | + |
| Citrate | + |
| Raffinose | − |
| D-galactose | + |
| Lactose | − |
| Sucrose | + |
| Nitrogen Sources | |
| L-Histidine | − |
| L-Cysteine | ++ |
| L-Phenylalanine | + |
| L-Valine | + |
| Antibiotic Resistance | ||
|---|---|---|
| AK | Amikacin (30 µg) | − |
| ATM | Aztreonam (30 µg) | + |
| C | Chloramphenicol (30 µg) | − |
| CAZ | Ceftazidime (30 µg) | + |
| CIP | Ciprofloxacin (1 µg) | + |
| CO | Colisttin sulphate (10 µg) | + |
| E | Erythromycin (15 µg) | − |
| GM | Gentamamicin (10 µg) | + |
| IMI | Imipenem (10 µg) | − |
| K | Kanamycin (1000 µg) | − |
| PG | Penicillin G (10 µg) | + |
| PRL | Piperacillin (100 µg) | + |
| RP | Rifampicin (30 µg) | + |
| T | Tetracycline (30 µg) | − |
| VA | Vancomycin (5 µg) | + |
| S. No | Compound Name | RT | Molecular Formula | M.W | Area (%) | Applications | References |
|---|---|---|---|---|---|---|---|
| 1 | Cyclobutanol | 6.10 | C4H8O | 72.11 | 0.56 | Antibacterial | [23] |
| 2 | Cyclohexane, butyl- | 6.64 | C10H20 | 140.2 | 0.44 | Antimicrobial | [24] |
| 3 | Undecane, 5,7-dimethyl- | 7.61 | C13H28 | 184.3 | 0.41 | Antimicrobial | [25] |
| 4 | E-2-Decenal | 8.96 | C10H18O | 154.2 | 3.40 | Antimicrobial | [26,27,28] |
| 5 | Tetradecane | 9.08 | C14H30 | 198.3 | 3.40 | Anticandidal | [29] |
| 6 | Cyclohexane, 1,1′-(1,2-dimethyl) | 9.20 | C16H30 | 222.4 | 0.82 | Antimicrobial | [24] |
| 7 | Cyclohexane, hexyl- | 9.69 | C12H24 | 168.3 | 2.67 | Antimicrobial | [24] |
| 8 | Oxiranemethanol | 10.0 | C9H10O2 | 150.1 | 0.03 | Antibacterial | [30] |
| 9 | 2-Undecanone | 10.3 | C11H22O | 170.2 | 1.52 | Antimicrobial | [25] |
| 10 | 5-Eicosene | 11.4 | C20H40 | 280.5 | 2.57 | Anticancer | [31] |
| 11 | 3-Tetredecane | 11.7 | C14H28 | 196.3 | 7.48 | Antimicrobial | [25] |
| 12 | Tetredecane | 11.8 | C14H30 | 198.3 | 5.01 | Antimicrobial | [25] |
| 13 | Cyclohexane, 1,2,4,5-tetraethyl | 12.0 | C14H28 | 196.3 | 0.67 | Antimicrobial | [24] |
| 14 | Cyclohexane, octyl- | 12.7 | C14H28 | 196.3 | 2.04 | Antimicrobial | [24] |
| 15 | 1,1-Dichloro-2-dodecanol | 15.1 | C12H24Cl2O | 255.2 | 0.38 | Antifungal | [32] |
| 16 | Bis(3,5,5-trimethylhexyl) ether | 15.2 | C18H38O | 270.5 | 10.22 | Antifungal | [33] |
| 17 | Hexadecane | 15.3 | C16H34 | 226.4 | 3.92 | Antimicrobial | [23] |
| 18 | Cyclohexane, decyl- | 16.2 | C16H32 | 224.4 | 1.09 | Antimicrobial | [24] |
| 19 | 8-Pentadecanone | 16.4 | C15H30O | 226.4 | 2.29 | Hepatotoxic | [34] |
| 20 | 1-Dodecane | 17.9 | C12H26 | 170.3 | 0.33 | Antimicrobial | [32] |
| 21 | Bis (3,5,5-trimethylhexyl) ether | 17.9 | C18H38O | 270.5 | 7.29 | Antimicrobial | [33] |
| 22 | Eicosane | 18.0 | C20H42 | 282.5 | 1.86 | Antimicrobial | [3] |
| 23 | 8-Pentadecanone | 18.9 | C15H30O | 226.4 | 2.49 | Antimicrobial | [3] |
| 24 | Acrylic acid hexadecanyl ester | 19.4 | C19H36O2 | 296.2 | 0.89 | - | - |
| 25 | 1, 1, 1, 2-Tetrafluoro-2-tridecene | 19.6 | C13H22F4 | 254.3 | 0.08 | - | - |
| 26 | 1,2-Benzenedicarboxylic acid | 19.8 | C8H6O4 | 166.1 | 3.90 | Antimicrobial | [35] |
| 27 | Bis-(3,5,5-trimethylhexyl) ether | 20.2 | C18H38O | 270.5 | 6.78 | Antifungal | [33] |
| 28 | Bis-(3-oxo-6′-diethylamino-spi) | 20.5 | C48H40N2O7 | 756.9 | 0.42 | - | - |
| 29 | 5-Eicosene | 22.1 | C20H40 | 280.5 | 6.02 | Anticancer | [31] |
| 30 | Octacosane | 23.0 | C28H58 | 394.8 | 2.19 | Antitumor | [36] |
| 31 | Dotriacontane | 23.9 | C32H66 | 450.9 | 5.91 | Antimicrobial | [37] |
| 32 | 2,4-Bis(α,α-dimethylbenzyl)phenol | 25.1 | C24H26O | 330.5 | 2.99 | Antihistaminic | [38] |
| 33 | 2, 2, 5, 5, 6-Pentamethyl-4, 7, 9-trioxabicyclo [4.2.1] nonane | 29.1 | C11H20O3 | 200.2 | 3.50 | - | - |
| 34 | Dodecane, 1,1-difluoro | 30.2 | C12H24F2 | 206.3 | 2.27 | Anticancer | [39] |
| 35 | 2, 4, 6–Cycloheptatrien-1-one | 31.1 | C7H6O | 106.1 | 0.61 | Antibacterial | [40] |
| 36 | Dodecane, 1,1-difluoro | 31.6 | C12H24F2 | 206.3 | 3.26 | Anticancer | [38] |
| Bacterial Pathogens (mm) | |||||
|---|---|---|---|---|---|
| Concentrations | 5 µg | 10 µg | 40 µg | 80 µg | |
| Klebsiella pneumoniae (ATCC 13883) | 8 ± 1 d | 11 ± 1.5 c | 15 ± 1.1 b | 17.5 ± 1.2 a | |
| Pseudomonas aeruginosa (ATCC 27853) | - | 8.5 ± 0.14 b | 12 ± 0.15 a | 14 ± 16 a | |
| Salmonella typhi (ATCC 14028) | 8 ± 1.3 d | 10 ± 1 c | 13 ± 1 b | 1.6 ± 0.9 a | |
| Streptococcus pneumoniae (ATCC 49619) | 9 ± 1 c | 10 ± 2 bc | 12 ± 1.5 b | 17 ± 1 a | |
| Staphylococcus aureus (ATCC 25923) | 7 ± 1.3 c | 8.5 ± 1.5 c | 12 ± 1 b | 18 ± 1.2 a | |
| Fungal Pathogen (mm) | |||||
| Concentrations | 20 µg | 40 µg | 80 µg | 200 µg | 400 µg |
| Candida albicans | 7 ± 1.5 c | 8 ± 2 c | 13 ± 1.9 b | 15 ± 1.5 b | 21 ± 1.6 a |
Publisher’s Note: MDPI stays neutral with regard to jurisdictional claims in published maps and institutional affiliations. |
© 2022 by the authors. Licensee MDPI, Basel, Switzerland. This article is an open access article distributed under the terms and conditions of the Creative Commons Attribution (CC BY) license (https://creativecommons.org/licenses/by/4.0/).
Share and Cite
Al-Enazi, N.M.; Abdel-Raouf, N.; Alharbi, R.M.; Sholkamy, E.N. Metabolic Profiling of Streptomyces sp. Strain ess_amH1 Isolated from Apis mellifera yemintica’s Gut Microbiome, and Its Anticancer Activity against Breast Cancer (MCF7) and Hepatocarcinoma (HepG2) Cell Lines, as Well as Antimicrobial Activity. Appl. Sci. 2022, 12, 12257. https://doi.org/10.3390/app122312257
Al-Enazi NM, Abdel-Raouf N, Alharbi RM, Sholkamy EN. Metabolic Profiling of Streptomyces sp. Strain ess_amH1 Isolated from Apis mellifera yemintica’s Gut Microbiome, and Its Anticancer Activity against Breast Cancer (MCF7) and Hepatocarcinoma (HepG2) Cell Lines, as Well as Antimicrobial Activity. Applied Sciences. 2022; 12(23):12257. https://doi.org/10.3390/app122312257
Chicago/Turabian StyleAl-Enazi, Nouf Mohammed, Neveen Abdel-Raouf, Reem Mohammed Alharbi, and Essam Nageh Sholkamy. 2022. "Metabolic Profiling of Streptomyces sp. Strain ess_amH1 Isolated from Apis mellifera yemintica’s Gut Microbiome, and Its Anticancer Activity against Breast Cancer (MCF7) and Hepatocarcinoma (HepG2) Cell Lines, as Well as Antimicrobial Activity" Applied Sciences 12, no. 23: 12257. https://doi.org/10.3390/app122312257
APA StyleAl-Enazi, N. M., Abdel-Raouf, N., Alharbi, R. M., & Sholkamy, E. N. (2022). Metabolic Profiling of Streptomyces sp. Strain ess_amH1 Isolated from Apis mellifera yemintica’s Gut Microbiome, and Its Anticancer Activity against Breast Cancer (MCF7) and Hepatocarcinoma (HepG2) Cell Lines, as Well as Antimicrobial Activity. Applied Sciences, 12(23), 12257. https://doi.org/10.3390/app122312257

